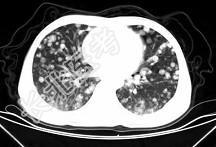

试题详情
- 单项选择题男,42岁, 肝区痛一月余,最近二周咯血丝痰, 胸部CT如图,最可能的诊断为 ( )

A、葡萄球菌肺炎
B、过敏性肺炎
C、结节病
D、肺转移瘤
E、韦格肉芽肿
关注下方微信公众号,搜题查看答案

热门试题
- 可引起高渗性缺水的有A、静脉输入大量高渗
- 尿量在多少以上即说明休克已纠正A、20m
- 手术矫正漏斗胸的最佳时机为A、0~2岁B
- 慢性脓胸行一期脓胸和病肺切除的指征包括A
- 下列症状中不是低血钾临床表现的是A、肌肉
- 源于骨组织的胸壁肿瘤,20%及80%的原
- 下列各项中,呼吸性酸中毒的常见病因是A、
- 1、最可能的诊断是2、如果患者进行了手术
- 女性,47岁, 门脉高压症引起食管、胃底
- 1、应考虑下列哪项诊断2、应进行下列哪项
- 电视胸腔镜手术时除配备胸腔镜手术设备外,
- 在图所示正常胸部X线影像图像上,该英文字
- 全胃肠外营养的要求是A、氮(g):热(k
- 男性,60岁, 进行性吞咽困难6个月,左
- 食管下端静脉曲张X线表现A、食管黏膜增粗
- 腐蚀性食管灼伤者,如早期发现有长管状狭窄
- 患者男,因十二指肠溃疡伴幽门梗阻2年,每
- 血胸病人发热,胸穿液行涂片染色镜检发现红
- 感染性休克的治疗中最重要的治疗是A、补充
- 男性,9岁,学校体格检查胸透发现胸部有异